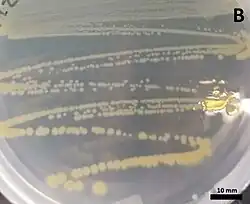

Massilia aerilata
| Massilia aerilata | ||
|---|---|---|
| ||
| Taxonomía | ||
| Dominio: | Bacteria | |
| Reino: | Pseudomonadati | |
| Filo: | Pseudomonadota | |
| Clase: | Betaproteobacteria | |
| Orden: | Burkholderiales | |
| Familia: | Oxalobacteraceae | |
| Género: | Massilia | |
| Especie: |
Massilia aerilata Weon et al. 2008 | |
Massilia aerilata es una especie de bacteria gramnegativa del género Massilia. Fue descrita en el año 2008. Su etimología hace referencia a llevada por el aire.[1] Es aerobia y móvil por flagelo polar. Tiene un tamaño de 0,7-1 μm de ancho por 1,5-3 μm de largo. Forma colonias de color amarillo claro, redondas y convexas. Crece en agar R2A, NA y TSA, pero no en MacConkey. Catalasa y oxidasa positivas. Temperatura de crecimiento entre 5-35 °C, óptima de 28 °C. Tiene un contenido de G+C de 68,9%. Se ha aislado de una muestra de aire en Suwon, Corea del Sur.[2]
Referencias
- ↑ Weon, Hang-Yeon; Kim, Byung-Yong; Son, Jung-A.; Jang, Han Byul; Hong, Sung Kee; Go, Seung-Joo; Kwon, Soon-Wo (2008-06). «Massilia aerilata sp. nov., isolated from an air sample». International Journal of Systematic and Evolutionary Microbiology 58 (Pt 6): 1422-1425. ISSN 1466-5026. PMID 18523189. doi:10.1099/ijs.0.65419-0. Consultado el 4 de febrero de 2023.
- ↑ «Leibniz Institute DSMZ: Details». www.dsmz.de. Consultado el 25 de abril de 2025.